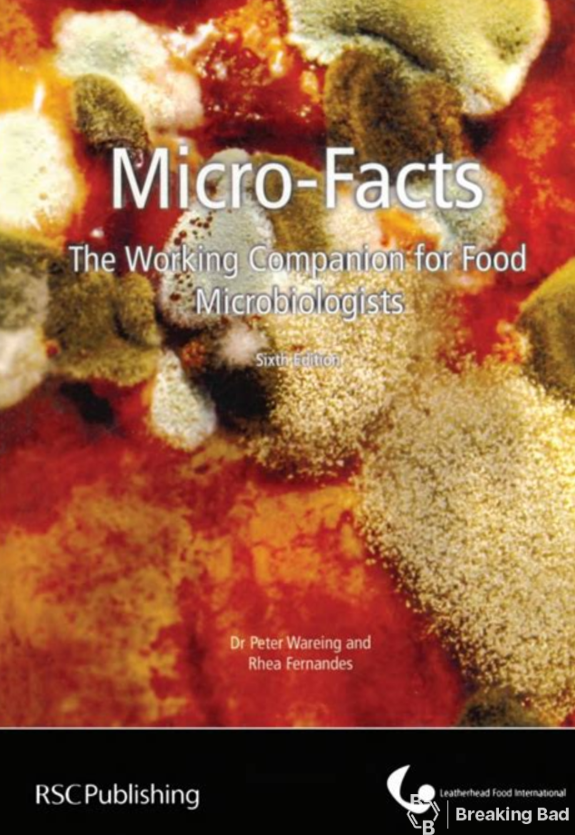

Peter Wareing, Rhea Femandes. MICRO-FACTS. 6th Ed. RSC, 2007

Peter Wareing, Rhea Femandes. MICRO-FACTS. 6th Ed. RSC, 2007
No permission to download
- Author GhostChemist
- Creation date
More ads from GhostChemist
-
Jon Heidt, Johannes Wheeldon. Visions of Cannabis Control. 2023Jon Heidt, Johannes Wheeldon. Visions of Cannabis Control. 2023
-
John S. Torday, William B. Miller Jr. The Singularity of Nature. RSC, 2021John S. Torday, William B. Miller Jr. The Singularity of Nature. RSC, 2021
-
John H. Duffus, Howard G. J. Worth. Fundamental Toxicology. RSC, 2006John H. Duffus, Howard G. J. Worth. Fundamental Toxicology. RSC, 2006
-
John Emsley. Molecules of Murder. Criminal Molecules and Classic Cases. RSC, 2016John Emsley. Molecules of Murder. Criminal Molecules and Classic Cases. RSC, 2016
-
J. Kästner. Tunnelling in Molecules. Nuclear Quantum Effects from Bio to Physical Chemistry. RSC 2021J. Kästner. Tunnelling in Molecules. Nuclear Quantum Effects from Bio to Physical Chemistry. RSC 2021
About Us
Our team brings together the best specialists from different fields.
We are ready to share our experience, discuss difficult issues and find new solutions.
